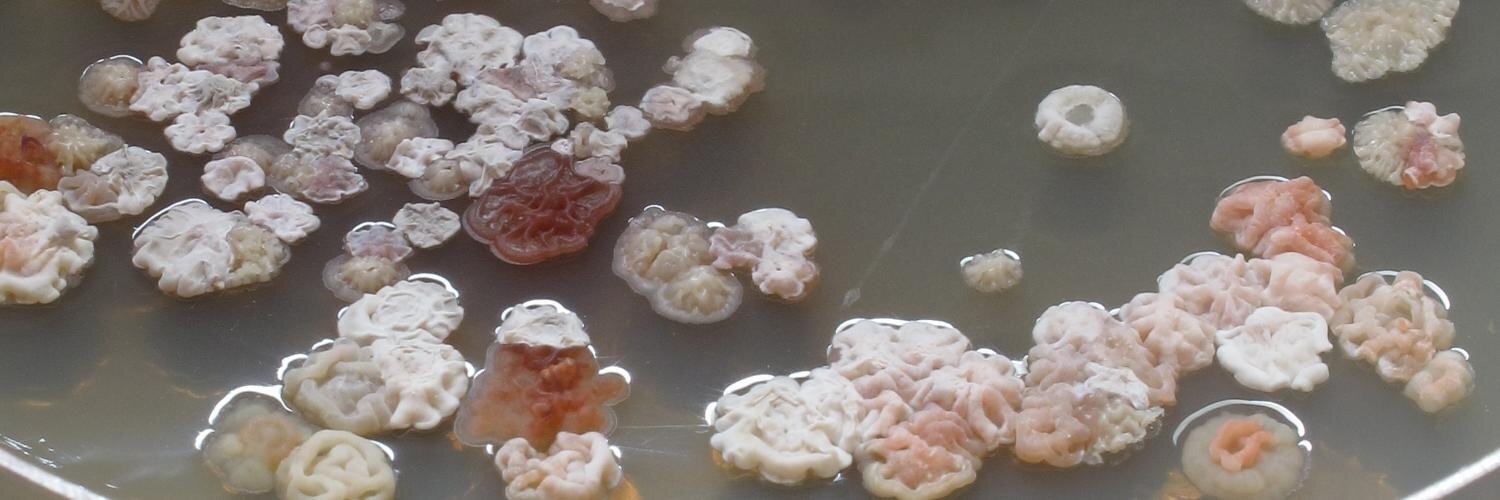
Kai Blin banner

Kai Blin
17.1K posts

Kai Blin
@kaiblin
Microbiology PhD, co-author of antiSMASH, Open Source geek, views are my own. @[email protected]
Denmark Katılım Mart 2010
460 Takip Edilen1.5K Takipçiler

@jankosinski I seem to remember looking this up, and apparently the reason ChatGPT likes these words is because they are overrepresented in scientific texts, way before GenAI was a thing
English

A big shoutout to @marnixmedema for the great collaboration over the past 15 years, here’s to millions of more jobs to run in the coming decades.
English

We hit an #antiSMASH milestone just in time for my talk on about an hour: 2 million jobs processed on the public web service, in a little under 15 years of its existence.
I’m super happy to have the opportunity to build a tool that turned out to be so useful to the community.

English

First secondary metabolite talk at #GiMMES2024 and #antiSMASH mentioned. Before AlphaFold, too.
English

I might be missing something obvious, but is there a place to let @haveibeenpwned know about apparent new breaches? I’m sitting here with a notice in my inbox about a breach of one of my accounts that HIBP doesn’t list yet…
English

Hey @PLOSONE, that’s the second time in two weeks that I, a computational biologist, was invited to review papers with economy and political policy topics.
Do you still care about where reviews come from? Because once is a fluke, but twice starts looking like a pattern.
English

We're currently seeing some sort of sporadic network outages for the servers we're running #antiSMASH on. I'm unclear on what's happening at the moment.
English

Carlos Acevedo-Rocha from @DTUBiosustain presenting ProteusAI, a tool to make ML more accessible for protein engineers #theautomatedscientist2024
English

DB points out the importance of considering codon diversity, not amino acid diversity when designing novel protein sequences. #theautomatedscientist2024
English

Douglas Kell @dbkell talking about the necessity of navigating sequence space intelligently by using active learning #theautomatedscientist2024
English

KW ending up with a prediction that AI won't replace scientists, but will replace scientists that won't use AI #theautomatedscientist2024
English

KW now rocking a live demo of their prototype generative protein design tool. I'm impressed, even if the prototype is still a bit rough on the edges. #theautomatedscientist2024
English

KW: Frequently you can see if your model is working by looking at training graphs, before even hitting the lab. #theautomatedscientist2024
English

KW pitching a "one model to rule them all" approach. This runs inverse to what I currently see to be the trend, so I'm interested in how that is going to work out. #theautomatedscientist2024
English

Kathy Wei making the point that developing new drugs is following the inverse Moore's Law, getting ever more expensive to create. #theautomatedscientist2024
English

Interesting discussion around the effect of being able to easily generate highly active enzymes with relatively low sequence similarities will have on the current IP landscape, where patent protection usually only covers up to 15 % similarity #theautomatedscientist2024
English

AF showing that at the moment latent space exploration still outperforms diffusion-based models, but is convinced that once we figure out how to nudge diffusion models into the right direction, lots of new interesting protein sequences will happen #theautomatedscientist2024
English


